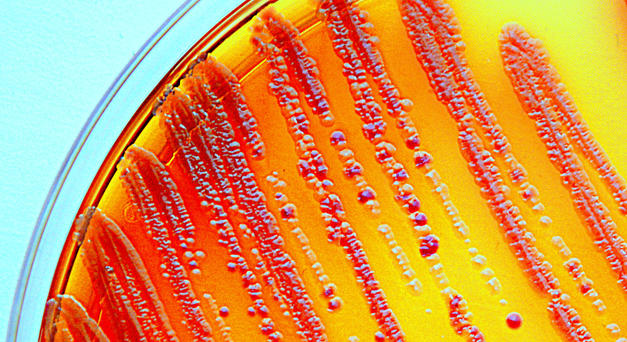
Lutte contre l’antibiorésistance : ce que peut apporter la dispensation à l’unité

- Accueil ›
- Législation ›
- Dispensation ›
- Lutte contre l’antibiorésistance : ce que peut apporter la dispensation à l’unité
© Getty Images/iStockphoto
Lutte contre l’antibiorésistance : ce que peut apporter la dispensation à l’unité
C’est une recommandation qui, sans la nommer, intervient en faveur de la dispensation de médicaments antibiotiques à l’unité. Dans son rapport d’avril 2022 intitulé « Mieux cibler l’antibiothérapie : un impératif majeur pour notre système de santé », la Fondation Concorde préconise une nouvelle approche pour lutter contre l’antibiorésistance.
« L’émergence de résistances peut être extrêmement rapide. Dès les premiers jours, une antibiothérapie a un impact sur la flore microbienne des patients, rappelle ce cercle de réflexion indépendant et émetteur de propositions pour les décideurs politiques. La consommation d’antibiotiques est le principal facteur d’émergence de résistances. C’est donc le premier levier effectif sur lequel on peut jouer ». Il est ainsi préconisé de réduire les indications (en ne traitant que les patients qui en ont besoin) et la durée des traitements.
La Fondation Concorde recommande de se porter sur une durée de traitement individualisée. Il n’est pas souhaitable que le patient aille jusqu’au bout d’une boîte pour « ne pas gâcher » alors lorsque la durée de prescription est inférieure au nombre de prises possibles dans le conditionnement standard. A contrario, lorsque des médicaments restent, il y a un risque potentiel de rejet dans l’environnement.
Certains médecins hospitaliers pratiquent déjà cette individualisation. « Dans notre service, nous avons choisi de baisser la durée à 3 jours pour les patients en bon état de santé. Les patients immunodéprimés sont traités plus longtemps, explique le Pr Aurélien Dinh, infectiologue à l’hôpital de Garches (Hauts-de-Seine). Lorsque les patients vont bien, selon quelques critères objectifs très simples, nous arrêtons l’antibiothérapie. Ces critères sont la fréquence cardiaque, la fréquence respiratoire, la saturation et la tension artérielle. »
De façon générale, les durées de traitement antibiotique sont très mal codifiées. Dans le cas des infections respiratoires, il y a quelques années, la durée de traitement préconisée était de 10 à 15 jours, voire de 3 semaines, lorsque les indications étaient incertaines, pointe la Fondation Concorde.
Plusieurs facteurs pourraient permettre cette individualisation des traitements : le suivi du patient par le biais d’une plateforme opérable par des auxiliaires de santé et un recours massif aux tests rapides d’orientation diagnostique (TROD) en pharmacie, souligne ce cercle de réflexion.
- Comptoir officinal : optimiser l’espace sans sacrifier la relation patient
- Reishi, shiitaké, maitaké : la poussée des champignons médicinaux
- Budget de la sécu 2026 : quelles mesures concernent les pharmaciens ?
- Cancers féminins : des voies de traitements prometteuses
- Vitamine A Blache 15 000 UI/g : un remplaçant pour Vitamine A Dulcis





